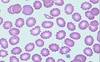
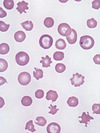
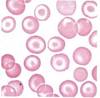
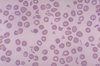

Haematology Flashcards
(25 cards)
Causes of anaemia
MICROCYTIC (MCV <80fL) - Thalassemia - ACD - IDA - Lead poisoning - Sideroblastic NORMOCYTIC (MCV 80-100fL) - haemorrhage - haemolysis - chronic renal failure - BM failure (infiltration/hypoplasia) - ACD MACROCYTIC (MCV >100fL) - hypothyroid - haemolysis - myelodysplasia - megaloblastic (B12/folate) - liver disease
How to differentiate ACD from IDA?
Iron studies !!!!
IDA
- serum Fe ↓
- transferrin ↑
- TIBC ↑
- saturation ↓
- serum ferritin ↓↓↓
ACD
- serum Fe ↓
- transferrin ↓
- TIBC ↓
- saturation ↓
- serum ferritin normal/↑
Reed stern-berg cells
Non-Hodgkin’s lymphoma
Anisocytosis, pencil poikilocytes
IDA
↑ unconjugated bilirubin, ↑ LDH, ↑ reticuloctyes, low haptoglobin
Haemolysis
Old, calcium raised, renal impairment, anaemia, bone disease
Myeloma !!!
Increased blood volume, viscosity, splenomegaly
Polycythemia vera
Philadelphia Chromosome
CML
Auer rods
AML
CD10 phenotype
ALL
What is von Willebrands disease?
- an inherited condition that results when the blood lacks functioning von Willebrand factor, a protein that helps the blood to clot and also carries another clotting protein, factor VIII. - It is usually milder than hemophilia and can affect both males and females
What is factor V Leiden?
INCREASED TENDENCY TO FORM CLOTS - Factor V Leiden is the name of a specific gene mutation that results in thrombophilia - People with factor V Leiden thrombophilia have a higher than average risk of developing a DVT - only about 10 percent of individuals with the factor V Leiden mutation ever develop abnormal clots.
Chronic kidney disease
- Burr cells/echinocytes
- ↓L-carnitine which is important for normal BM function = suppressed BM
Acanthocytes
- seen in liver disease

Stomatocyte
- often seen in alcohol induced liver disease
Target cells or codocytes
are red cells with central staining with precipitated haemoglobin seen in conditions with abnormal haemoglobin as well as cell membrane
- Sickle cell disease
- thalassaemia
- iron deficiency anaemia
- liver disease
Signs + symptoms of subacute combined degeneration of the cord? How to avoid this when treating patients with megaloblastic anaemia?
- dementia + peripheral neuropathy
- lack of vibration sense
- due to B 12 def - megaloblastic anaemia
Treatment
- replenish B12 before giving folate
- might only have a little bit of B12, so if you give folate the BM might use up the last bit of B12 and the patient could get this condition
Conditions related to JAK2 mutation?
- polycythemia vera
- primary myelofibrosis
- essential thrombocythemia
Myelofibrosis
- bone marrow is replaced by scar tissue (fibrosis)
- because of the fibrosis, the bone marrow cannot produce enough normal blood cells
- Pancytopenia with teardrop cells
- Has the ability to turn into AML over time
Shistocytes
- RBC fragments
- due to haemolysis

Howell-Jolly bodies - contain nuclear remnants
Causes are:
- Post splenectomy
- Leukaemia
- Megaloblastic anaemia
- Iron deficiency anaemia
Causes of high ESR
- Multiple myeloma
- Tuberculosis
- Metastatic malignancy
- Temporal arteritis
- Polymyalgia rheumatica


